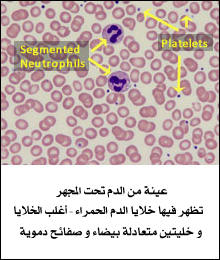

تحليل تِعداد خلايا الدم البيضاء
White Blood Cell (WBC) Count; Leukocyte Count
الغرض من هذا التحليل:
يتم إجراء هذا التحليل لفحص أو لتشخيص الإصابة بمجموعة مُتنوّعة من الحالات المرضيّة التى يُمكنها أن تؤثر على خلايا الدم البيضاء (WBCs) ، مثل العدوى أو الالتهاب أو المرض الذى يؤثر على إنتاج أو مدى بقاء خلايا الدم البيضاء. و لمُراقبة علاج أمراض الدم أو لمُراقبة العلاج المعروف عنه أنه يؤثر على خلايا الدم البيضاء.
يُطلب منك إجراء هذا التحليل فى الحالات التالية:
يُطلب منك إجراء هذا التحليل كجُزء من تحليل صورة الدم الكاملة (CBC) ، و عندما تقوم بإجراء فحص صِحّى روتينى. و عندما تُعانى من أى عدد من العلامات و الأعراض المرضيّة التى قد تتعلّق بإصابتك بحالة مرضيّة تؤثر على خلايا الدم البيضاء ، مثل العدوى أو الالتهاب أو السرطان. و عندما تُصاب بحالة مرضيّة ما أو كنت تتلقّى علاجا معروف عنه أنه يؤثر على خلايا الدم البيضاء.
العينة المطلوبة لإجراء التحليل:
عينة من الدم يتم سحبها من وريد فى ذراعك أو من خلال وخز الإصبع (فى الأطفال و البالغين) أو وخز الكاحل (كعب القدم) (فى الأطفال حديثى الولادة).
تحضيرات قبل إجراء التحليل:
لا يوجد.
كيف يتم التحليل و ماذا يبحث عنه الطبيب؟
تُسمّى خلايا الدم البيضاء (WBCs) أيضا الكُريات البيضاء (leukocytes) ، و هى خلايا توجد فى الدم و فى الجهاز الليمفاوى و فى الأنسجة ، و تُمثّل جُزءا مهما من الجهاز المناعى للجسم. فهى تساعد فى مُكافحة العدوى و لها دوْر أيضا فى حالات الالتهاب و استجابة الجسم تجاه الحساسيّة و الحماية ضد الأوْرام السرطانيّة. يقوم تحليل تِعداد خلايا الدم البيضاء (WBC count) بجمع عدد خلايا الدم البيضاء الموجودة فى عينة دم لدى شخص ما. و يُمثّل واحدا من بين تحاليل عديدة يشملها تحليل صورة الدم الكاملة (CBC) و غالبا ما يُستخدم فى التقييم الصِحّى العام لشخص ما.
يتكوَّن الدم من أنواع قليلة مختلفة من الخلايا العائمة فى سائل يُدعَى سائل البلازما (plasma). بالإضافة إلى خلايا الدم البيضاء (WBCs) ، فهناك خلايا الدم الحمراء (RBCs) و الصفائح الدمويّة (Platelets). يتم إنتاج هذه الخلايا فى نُخاع العظام و يتم إفرازها لاحقا فى مجرَى الدم. هناك خمسة أنواع من خلايا الدم البيضاء ، و لكل منها وظيفة مختلفة.
يُشار إلى ثلاثة أنواع من خلايا الدم البيضاء بـ "الخلايا المُحبّبة granulocytes" بسبب وجود حُبيْبات فى سائلها الخلَوى (سايتوبلازم cytoplasm). تقوم هذه الحُبيْبات بإفراز مواد كيميائيّة و مواد أخرى كجُزء من الاستجابة المناعيّة. تشمل الخلايا المُحبّبة: الخلايا المُتعادلة (neutrophils) ، و هى تُكوِّن العدد الأكبر من خلايا الدم البيضاء التى تسرى فى الدم ، و خلايا الحِمضات (eosinophils) و الخلايا القاعِديّة (basophils). النوعان الآخران من خلايا الدم البيضاء هما الخلايا الأحاديّة (monocytes) و الخلايا الليمفاويّة (lymphocytes). تنقسم الخلايا الليمفاويّة (lymphocytes) إلى ثلاثة أنواع فرعيّة: الخلايا الليمفاويّة (B) التى تُنتج الأجسام المُضادة (تُعرَف أيضا بالجلوبولينات المناعيّة immunoglobulins) ، و الخلايا الليمفاويّة (T) و الخلايا القاتلة الطبيعية (natural killer cells - NK).
عندما يكون هناك عدوى أو التهاب فى مكان ما بالجسم ، يقوم نخاع العظام بإنتاج المزيد من خلايا الدم البيضاء و إفرازها فى الدم ، و من خلال عملية مُعقّدة ، تتحرك تلك الخلايا إلى موقع العدوى أو الالتهاب. بمُجرّد شفاء الحالة ، ينحسر إنتاج خلايا الدم البيضاء بواسطة نُخاع العظام و يهبط عدد خلايا الدم البيضاء إلى مستواه الطبيعى مرة أخرى.
بالإضافة إلى الإصابة بالعدوى و بالالتهاب ، فهناك عدد من الحالات المرضيّة التى يُمكنها أن تؤثر على إنتاج خلايا الدم البيضاء بواسطة نُخاع العظام أو على مدى بقائها فى الدم ، مثل الأوْرام السرطانيّة أو أمراض المناعة الذاتيّة ، مما يؤدى إما إلى زيادة أو نقص عدد خلايا الدم البيضاء فى الدم. إن تِعداد خلايا الدم البيضاء إلى جانب المُكوّنات الأخرى لتحليل صورة الدم الكاملة (CBC) ، يُنبّه الطبيب المعالج بالمشاكل الصِحيّة المُحتملة. غالبا ما يتم تفسير النتائج بالترافُق مع نتائج فحوصات إضافية ، مثل تحليل تبايُن خلايا الدم البيضاء (WBC differential) و فحص شريحة الدم (blood smear). يُمكن لتحليل تبايُن خلايا الدم البيضاء أن يُخبر الطبيب المعالج بأى نوع من خلايا الدم البيضاء قد يكون منخفضا أو يكون مرتفعا ، و يُمكن لفحص شريحة الدم أن يكشف عن وجود خلايا دم بيضاء غير طبيعية و/أو غير مُكتملة النموْ (غير ناضجة).
إذا أشارت النتائج الظاهرة إلى وجود مشكلة ما ، فقد يتم إجراء مجموعة واسعة النِطاق من الفحوصات الأخرى بغرض المساعدة فى تحديد السبب. عادةً ما سيأخذ الطبيب المعالج فى اعتباره العلامات و الأعراض المرضيّة الظاهرة على شخص ما و تاريخه المرضى و نتائج فحصه البدنى بغرض تقرير ماهيّة الفحوصات الأخرى التى قد يكون من الضرورى إجراؤها. على سبيل المثال و على حسب الحاجة ، يتم أخذ خُزعة (عينة) من نسيج نُخاع العظام لتقييم حالة النُخاع (bone marrow biopsy).
كيف يتم جمع العينة اللازمة لإجراء هذا التحليل؟
يتم أخذ عينة الدم من وريد بالذراع بواسطة إبرة (حقنة) أو جمع الدم من خلال وخز إصبع اليد (بالنسبة للأطفال و البالغين) أو من خلال وخز الكاحل (كعب القدم) (بالنسبة للأطفال حديثى الولادة).
هل هناك أى تحضيرات لازمة قبل إجراء التحليل للتأكد من جودة العينة المستخدمة؟
ليس هناك حاجة إلى تحضيرات خاصة قبل إجراء هذا التحليل. قُم بإخبار طبيبك المعالج بأى أدوية قمت بتعاطيها مؤخّرا (سواء كانت بوَصفة طبية أو بدونها). يُمكن لبعض الأدوية أن تُسبب ارتفاعا أو انخفاضا فى تُعداد خلايا الدم البيضاء.
كيف تتم الاستفادة من هذا التحليل؟
يُستخدم تحليل تِعداد خلايا الدم البيضاء (WBC count) كجُزء من تحليل صورة الدم الكاملة (CBC) بغرض:
◊ التقصّى عن نِطاق واسع من الأمرض.
◊ المساعدة فى تشخيص الإصابة بعدوى ما أو بالتهاب ما. قد يُستخدم أيضا لتحديد وجود أمراض أخرى تؤثر على خلايا الدم البيضاء ، مثل حالات الحساسيّة أو مرض سرطان الدم (leukemia) أو أمراض المناعة الذاتيّة ، على سبيل المثال و ليس الحصر.
◊ مُراقبة مسار الحالات المرضيّة مثل الأمراض المذكورة أعلاه. و مُراقبة استجابة الجسم تجاه مجموعة مُتنوّعة من العلاجات و/أو مُراقبة الأداء الوظيفى لنُخاع العظام. بعض العلاجات ، مثل العلاج الكيماوى و الإشعاعى معروف عنها أنها تؤثر على خلايا الدم البيضاء و قد تتم مُراقبتها باستخدام تحاليل تِعداد خلايا الدم البيضاء.
توجد خلايا الدم البيضاء فى الدم و فى الجهاز الليمفاوى و فى الأنسجة و تُمثّل جُزءا مهما فى الجهاز المناعى للجسم. تقوم بعض الأمراض باستثارة استجابة الجهاز المناعى و تُسبب زيادة فى عدد خلايا الدم البيضاء. تؤثر بعض الحالات المرضيّة الأخرى على إنتاج خلايا الدم البيضاء بواسطة نُخاع العظام أو على بقائها فى الدوْرة الدمويّة ، مما يؤدى إلى إما زيادة أو نقص فى عدد خلايا الدم البيضاء التى تسرى فى الدم.
يُمكن أن يُشير تِعداد خلايا الدم البيضاء إلى وجود مرض ما أو حالة مرضيّة ما تؤثر على خلايا الدم البيضاء ، و لكنه لا يتمكّن من تحديد السبب الكامِن وراءها. قد يتم إجراء العديد من الفحوصات الأخرى فى نفس توقيت أو كفحوصات متابعة تالية لظهور نتيجة غير طبيعية بغرض المساعدة فى وَضع تشخيص للحالة. قد تشمل بعض من تلك الفحوصات الإضافيّة تحليل تبايُن خلايا الدم البيضاء (WBC differential) و فحص شريحة الدم (blood smear) ، أو فى الحالات العنيفة ، يتم فحص نُخاع العظام. قد يُشير تحليل تبايُن خلايا الدم البيضاء إلى نوع خلايا الدم البيضاء المنخفض أو المرتفع ، بينما يُمكن لفحص شريحة الدم و/أو لفحص خُزعة (عينة) نُخاع العظام أن يكشف عن وجود خلايا دم بيضاء غير طبيعية و/أو غير مُكتملة النموْ (غير ناضجة).
متى يُطلب إجراء هذا التحليل؟
عادةً ما يُطلب إجراء تحليل تِعداد خلايا الدم البيضاء كجُزء من تحليل صورة الدم الكاملة (CBC) ، و الذى قد يتم إجراؤه عندما يخضع شخص ما للفحص الصِحّى الروتينى. قد يتم إجراؤه عندما يُعانى شخص ما من علامات و أعراض الإصابة بعدوى ما و/أو التهاب ما مثل ما يلى:
◊ حُمّى (ارتفاع درجة حرارة الجسم) ، و ارتعاشات.
◊ أوْجاع و ألم فى الجسم.
◊ صُداع.
◊ مجموعة مُتنوّعة من العلامات و الأعراض المرضيّة الأخرى التى تعتمد على موقع الإصابة بالعدوى أو الالتهاب المُشتبه بهما.
๏ قد يتم إجراء التحليل عندما تكون هناك علامات و أعراض مرضيّة يعتقد الطبيب المعالج فى كَوْنها قد تتعلّق بوجود مرض فى الدم أو مرض مناعى ذاتى أو نقص فى المناعة.
๏ قد يُطلب إجراء تحليل تِعداد خلايا الدم البيضاء فى الغالب على فترات زمنيّة مُنتظمة بغرض مُراقبة شخص ما تم تشخيص حالته على أنها إصابة بعدوى ما أو بمرض فى الدم أو بمرض مناعى أو بحالة مرضيّة أخرى تؤثر على خلايا الدم البيضاء. قد يُطلب أيضا إجراؤه بصِفة دوْريّة لمُراقبة مدى فاعِليّة العلاج الموصوف أو عندما يكون من المعروف عن علاج ما مُعيّن بأنه يؤثر على خلايا الدم البيضاء ، مثل العلاج الإشعاعى أو العلاج الكيماوى.
ما هى نتائج هذا التحليل و ماذا تعنى؟
يُشير تِعداد خلايا الدم البيضاء إلى وجود ارتفاع أو انخفاض فى التِعداد الإجمالى لخلايا الدم البيضاء. سيأخذ الطبيب المعالج نتائج تحليل تِعداد خلايا الدم البيضاء سَويا مع نتائج المُكوّنات الأخرى لتحليل صورة الدم الكاملة (CBC) بالإضافة إلى عدد من العوامل الأخرى ، مثل الفحص البدنى و التاريخ المرضى و العلامات و الأعراض المرضيّة الظاهرة.
إن وجود تِعداد مرتفع لخلايا الدم البيضاء ، و الذى يُدعَى فرط الكُريات البيضاء (leukocytosis) ، قد يكون ناتجا عن عدد من الحالات و الأمراض ، تشمل بعض الأمثلة ما يلى:
◊ العدوى ، و التى يكون سببها الأكثر شيوعا هو البكتيريا و بعض الفيروسات ، و بصورة أقل شيوعا بسبب الفِطريات و الطُفيْليات.
◊ الالتهابات أو الحالات الالتهابيّة ، مثل مرض التهاب المفاصل الروماتويدى (rheumatoid arthritis) أو مرض التهاب الأوْعية الدمويّة (vasculitis) أو مرض التهاب الأمعاء.
◊ مرض سرطان الدم (leukemia) ، و الأوْرام التى تُسبب التكاثُر المُفرِط لنُخاع العظام (myeloproliferative neoplasms).
◊ الحالات المرضيّة التى تؤدى إلى موت الأنسجة (النخر necrosis) ، مثل الإصابات و الحروق و الجراحات و الأزمة القلبيّة.
◊ الاستجابات تجاه حالات الحساسيّة (مثل حالات الحساسيّة و الربوْ asthma).
إن وجود تِعداد منخفض لخلايا الدم البيضاء ، و الذى يُدعَى نقص الكُريات البيضاء (leukopenia) ، يُمكن أن ينتج عن الإصابة بحالات مرضيّة مثل ما يلى:
◊ تلف نُخاع العظام (مثل المواد السامة و العلاج الكيماوى و العلاج الإشعاعى و الأدوية).
◊ أمراض نُخاع العظام: لا يقوم نُخاع العظام بإنتاج كميات كافية من خلايا الدم البيضاء ( مثل مُتلازمة خلل نُخاع العظام myelodysplastic syndrome ، أو نقص فيتامين B12 أو نقص حمض الفوليك).
◊ مرض سرطان الدم الليمفاوى (lymphoma) أو الأوْرام السرطانيّة الأخرى التى تنتشر فى نُخاع العظام.
◊ أمراض المناعة الذاتيّة: يقوم الجسم بمُهاجمة و تدمير خلايا الدم البيضاء الخاصة به (مثل داء الذئبة lupus).
◊ حالات نقص التغذية.
◊ حالات العدوى العنيفة (مثل مرض تعفُّن الدم sepsis).
◊ أمراض الجهاز المناعى ، مثل مرض نقص المناعة المُكتسبة (مرض الإيدز HIV) و الذى يقوم بتدمير الخلايا الليمفاويّة (T).
๏ عندما يتم استخدام تحاليل تِعداد خلايا الدم البيضاء لأغراض المُراقبة ، فإن ظهور سلسلة من تِعدادات خلايا الدم البيضاء المرتفعة أو المنخفضة بشكل غير طبيعى يُشير إلى أن الحالة المرضيّة أو المرض يزداد سوءا. بينما تُشير عوْدة تِعداد خلايا الدم البيضاء إلى مستواه الطبيعى إلى تحسُّن الحالة و/أو إلى فاعِليّة العلاج الموصوف.
هل هناك أشياء أخرى يجب أن أعرفها عن هذا التحليل؟
إذا قمت باستئصال الطُحال ، فقد يكون لديك ارتفاع دائم بسيط إلى مُتوسّط فى تِعداد خلايا الدم البيضاء.
يُمكن لمُمارسة التمارين الرياضيّة العنيفة أو التعرُّض لضغوط عاطفيّة أو بدنيّة شديدة أن يزيد من تِعداد خلايا الدم البيضاء ، و لكن لا يُستخدم التحليل لتقييم مثل هذه الحالات. قد يرتبط أيضا الشهر الأخير فى فترة الحمل و الولادة بزيادة مستويات خلايا الدم البيضاء.
فى الولايات المتحدة ، يرتبط تِعداد خلايا الدم البيضاء بعُمر الفرد و جنسه و عِرقه و إذا ما كان مُدخنا من عدمه. من الشائع فى كبار السِنّ ألا تتمكّن أجسامهم من زيادة إنتاج خلايا الدم البيضاء (فرط الكُريات البيضاء leukocytosis) كاستجابة لإصابتهم بالعدوى.
هناك الكثير من الأدوية التى تُسبب إما زيادة أو نقص فى تِعداد خلايا الدم البيضاء.
� هل يُمكن إجراء تحليل تِعداد خلايا الدم البيضاء (WBC count) على عيّنة بخلاف عينة الدم؟
نعم. قد يتم إجراء تحاليل تِعداد خلايا الدم البيضاء على العديد من أنواع سوائل الجسم المختلفة. إن السبب الشائع لإجراء التحليل على تلك العيّنات هو لتقييم منطقة الجسم المُصابة بالعدوى أو بالالتهاب بشكل مُباشر. على سبيل المثال ، إذا تم الاشباه فى الإصابة بمرض التهاب أغشية المُخ (التهاب السحايا meningitis) ، فعندئذ قد يتم إجراء تحليل تِعداد خلايا الدم البيضاء بالإضافة إلى تحليل تبايُن الخلايا (differential) على عينة من السائل الشوْكى (cerebrospinal fluid - CSF).
� إذا كان لدي نتيجة غير طبيعية لتحليل تِعداد خلايا الدم البيضاء ، فما الفحوصات الأخرى التى قد يطلبها منى طبيبى المعالج؟
قد تشمل الفحوصات العامة الأخرى التى يتم إجراؤها بغرض فحص حالتك الصِحيّة تحاليل الأيض الشاملة (comprehensive metabolic panel - CMP). اعتمادا على العلامات و الأعراض المرضيّة التى تُعانى منها و تاريخك المرضى و نتائج فحصك البدنى و الحالة المرضيّة المُشتبه فى إصابتك بها ، قد يختار طبيبك المعالج طلب إجراء مجموعة مُتنوّعة من الفحوصات الأخرى. تشمل بعض الأمثلة العامة القليلة ما يلى:
◊ العدوى البكتيريّة: يتم عمل اختبار مزرعة على عينة من المنطقة المُصابة (مثل اختبار مزرعة البول و مزرعة البلغم و مزرعة الدم) و اختبار الكشف عن البكتيريا السبحيّة.
◊ العدوى الفيروسيّة: اختبار الكشف عن الإصابة بداء كثرة الخلايا الأحاديّة (mononucleosis) و اختبار الكشف عن فيروس ابشتاين - بار (EBV).
◊ حالات الالتهاب: تحليل بروتين سى التفاعُلى (CRP) و اختبار سُرعة ترسيب الدم (ESR).
◊ أمراض المناعة الذاتيّة: اختبار الأجسام المُضادة للنواة (ANA).
◊ حالات الحساسيّة: اختبارات الحساسيّة.
◊ مرض سرطان الدم (leukemia): فحص خُزعة (عينة biopsy) من نسيج نُخاع العظام ، و اختبار التنميط المناعى (immunophenotyping) (مثل تِقنيَة القياس الخلَوى بالجرَيان) ، و تحليل الصِبغيات (الكروموسومات).